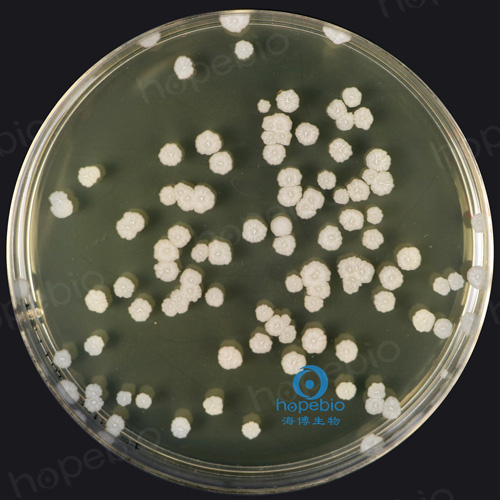

海博微信公众号
海博微信公众号
 海博天猫旗舰店
海博天猫旗舰店


 海博微信公众号
海博微信公众号
 海博天猫旗舰店
海博天猫旗舰店




引言
理论上,经过充分沸腾的白开水已杀灭了其中绝大部分的微生物。然而,绝对的“无菌”只存在于特定的条件下。当水被倒入杯中并开始静置时,将重新暴露于新的污染源之下。一旦水暴露于空气中,这杯隔夜水,早已不是最初倒满时的那杯水了。
一、初始的污染源
即便是经过高温煮沸的自来水,在沸腾的那一刻确实杀灭了绝大多数细菌、病毒等。但当水被倒入水杯,与空气接触的瞬间,就有被污染的风险。而市售的桶装纯净水或矿泉水,虽然出厂时微生物指标控制在极低的安全范围内,但也并非绝对的无菌真空。

图1 高温煮沸的自来水用营养琼脂倾注的结果
隔夜水中最初的微生物主要有三个来源:
1.空气降尘,空气并非空无一物,其中漂浮着无数细小的尘埃、颗粒物、花粉、真菌孢子以及细菌芽孢。这些微小的生命单位随时间的推移,沉降到水面上。细菌芽孢是某些细菌(如枯草芽孢杆菌)在恶劣环境下形成的休眠体,它们对干燥、紫外线和高温有极强的抵抗力。
图2 枯草芽孢杆菌的形态
2.杯壁的菌残留,无论杯子洗得多么干净,其微观表面总是存在一些沟壑和划痕,这些地方可能栖息着未被彻底清除的微量微生物生物膜残骸。当水注入,这些残留的微生物便被激活和稀释,进入水体。
3.我们的口腔,当我们直接用杯子喝水时,唾液会不可避免地回流入杯中。人的口腔有着复杂的微生物环境,栖息着多种细菌,如链球菌、乳酸杆菌等。哪怕只是轻微的一口,也足以向水中引入一个多样化的微生物群。
在夜晚的初期,这些初始细菌的数量还很少,它们静静地悬浮或沉在水底,等待着时机。
二、细菌的繁殖
夜晚,为这些微生物提供了绝佳的繁衍温床。光照消失、温度相对恒定、没有人为干扰,细菌的大量繁殖开始。
1.所需营养的来源
纯净水本身缺乏微生物生长所需的有机营养,但还存在其他途径。
溶解的有机物,即便是处理过的饮用水,也含有极微量的可溶性有机碳(DOC)。这些可能来自水源本身,或管道输送过程中的微量渗漏。
空气中的降尘,沉降的尘埃颗粒本身就是有机和无机营养的集合体,为微生物提供了“食物”。
唾液的回流,这是最重要的营养来源之一。唾液中含有蛋白质、糖类、电解质等丰富的营养物质。一杯被喝过的水,其营养水平远高于未喝过的,其微生物繁殖速度也因此呈几何级数增长。
2.种群爆发与生态演替
在适宜的室温下,细菌的繁殖是指数级的。一般细菌以无性二分裂的形式,在20-30分钟内分裂一次。经过8小时的夜晚,理论上一个细菌可以繁衍出数百万的后代。如图3,将隔夜水经过梯度稀释1000倍后接种1000μL水样于营养琼脂培养基中进行倾注。

图3 稀释后的隔夜水在营养琼脂中的倾注结果
那些能够最快适应水环境、繁殖周期短的细菌会迅速占据主导,例如一些常见的革兰氏阴性菌,如假单胞菌属的一些种类。它们对营养要求不高,能高效利用水中的微量有机物。随着种群密度增加,细菌之间开始相互作用。它们会分泌一些代谢产物,这些产物可能抑制某些竞争者,也可能为其他菌种创造生存条件。一些细菌会附着在杯壁上,开始尝试构建简单的生物膜前体结构。如果空气中落入了真菌孢子(如酵母菌或霉菌),在条件合适时,它们也会开始萌发、生长。真菌通常生长较慢,但它们能分解更复杂的物质。
微生物在生长的同时,也在不断进行新陈代谢。它们会向水中释放各种代谢产物,这是隔夜水口感发生变化和潜在健康风险的根源。有机酸,导致水可能产生一丝极其微弱的酸味或“馊味”;挥发性硫化物,某些细菌分解含硫氨基酸会产生类似臭鸡蛋的微量气体;胞外聚合物,这是形成生物膜的关键粘性物质,让水在触感上可能变得略微“粘稠”,虽然这种变化通常极其细微,难以被人体感官察觉。
三、如何处理隔夜水
隔夜水的变化不是一个静态的结果,而是一个动态的过程,受多种因素影响。隔夜通常指8-12小时。如果水放置超过24小时,微生物群落会进入稳定期或衰亡期,数量更为庞大,代谢废物积累更多,风险也随之增加。
了解了隔夜水的微观历程,我们不必过度恐慌,但应建立起更科学的饮水习惯。提倡即倒即饮,尽量喝新倒的水,这是最安全、口感最佳的选择;使用带盖水杯,如果需要将水放置一段时间,务必盖上盖子,这是最简单有效的防护措施;勤洗水杯,定期彻底清洗水杯,特别是杯口和杯壁,清除可能形成的生物膜。可以使用软布和洗涤剂,并定期用开水烫洗消毒;不喝“超长待机”水,放置超过24小时的水,尤其是被喝过的,建议直接倒掉;特殊人群需谨慎,对于婴幼儿、老年人、免疫力低下的人群,应严格避免饮用隔夜水,因为他们对病原微生物的抵抗力更弱。
四、相关培养基的采购
球盟会(中国)网页版有适用于饮用水相关细菌检验的相关培养基,客户可根据实际情况和用途进行选用。
|
产品编号 |
产品名称 |
规格 |
产品说明及用途 |
|
HB0119 |
250g |
用于饮用水,水源水中总大肠菌群的测定 |
|
|
HB0109 |
250g |
用于一般细菌培养、转种、复壮和增菌等 |
|
|
HB0167 |
250g |
用于饮用水中细菌总数的计数 |
注:本文属海博生物原创,未经允许不得转载。
下一篇:厌氧菌常用固体培养基及使用方法
| 相关文章: | |



